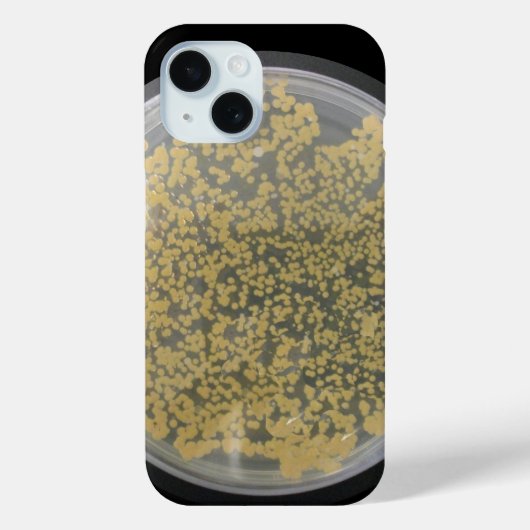
Bakterienkulturstein Bedeckt mit Kolonien Case-Mate iPhone Hülle (Rückseite)

40,60 €
pro Hülle
Bakterienkulturstein Bedeckt mit Kolonien Case-Mate iPhone Hülle
Produkt-Details anzeigenÜber Casemate Hüllen
Verkauft von
Über dieses Design
Bakterienkulturstein Bedeckt mit Kolonien Case-Mate iPhone Hülle
Eine Petrischale mit nährstoffhaltigem Agar und vielen hübschen, bezaubernden Bakterienkolonien schmücken dieses kultivierte Handy. Schauen Sie sich all diese kleinen Städte von Mikroorganismen an. Sind sie nicht süß? Wenn Sie ja sagten, dann sind Sie nur die Person, für die dieser Fall erstellt wurde. Du bist ein Profi und kannst eine Schleife fassen und wie ein Meister streak. Sehen Sie, wie Menschen auf Ihr Telefon starren, wie ein großes Fragezeichen über ihren Köpfen erscheint. Wenn sie fragen: "Was ist das?", können Sie sagen: "Es ist nur eine kleine Kultur." (vielleicht sagen Sie das nicht) Bild Copyright 2012 von Margaret E. Cmelik.
Automatische Übersetzung
Kundenrezensionen
4.5 von 5 Sternen Bewertung23 Bewertungen insgesamt
23 Bewertungen
Bewertungen für ähnliche Produkte
5 von 5 Sternen Bewertung
Von L.23. Mai 2017 • Geprüfter Kauf
Case-Mate Hülle, Apple iPhone 11, Tough
Creator Bewertung
I love the design, it matches very well my black Iphone. The case seems very stable and of good quality. the colors are just as expected and the print brings out the design very well.
4 von 5 Sternen Bewertung
Von B.7. Dezember 2012 • Geprüfter Kauf
Case-Mate Hülle, Apple iPhone 11, Tough
Bewertungsprogramm bei Zazzle
Die Verarbeitung der iPhone5 Schutzhülle ist wie erwartet sehr hochwertig. Da ich ein sehr kompliziertes Muster wählte war es nicht verwunderlich dass man eine leichte verpixelung entdeckt.
Ansonsten hochwertige Bedruckung die auch Farbecht ist.
Alle Daumen hoch!
5 von 5 Sternen Bewertung
Von E.22. Januar 2014 • Geprüfter Kauf
Case-Mate Hülle, Apple iPhone 11, Tough
Bewertungsprogramm bei Zazzle
Bestellt und gewartet.... und gewartet. Nach Ablauf der 21 Tage habe ich den Kundenservice von Zazzle kontaktiert und meine Bestellung wurde als "verloren gegangen" gemeldet. Angebot vom Service: entweder Geld zurück oder neuer Versand, dieses mal mit Express ohne weitere Kosten. Ich habe mich für die zweite Variante entschieden und innerhalb von einer Woche kam die Bestellung mit UPS an. Und was soll ich sagen... ich liebe diese Hülle. Die passt perfekt auf mein iPhone 5S (weiß). In der Hülle befindet sich eine dünne Gummi-Beschichtung zum Schutz, das iPhone wird dadurch aber nicht wesentlich kompakter... Klar macht so eine Hülle das Gerät immer ein bisschen dicker. Dafür sicherer Schutz vor Kratzern und beneidenswerte Optik. Ich bin gespannt wie mein Umfeld reagiert.
Als Entschädigung bekam ich vom Kundenservice sogar noch einen Gutschein für meine nächste Bestellung. Danke Zazzle! (:. Der Druck ist sehr klar, auch die Farben sind schön kräftig. Erwartet hatte ich mehr Goldtöne, in Echt sieht es etwas mehrnach Ocker aus - stört mich persönlich aber gar nicht. Die Oberfläche der Hülle glänzt schön und umschließt mein iPhone an den Kanten perfekt. Ich vermute fast, mit einem iPhone 5S in gold (meines ist silber) wirkt die Hülle noch besser! Ich bin auf jeden Fall sehr zufrieden. Man sagt nicht umsonst "was länge währt, wird endlich gut"!
Tags
Andere Informationen
Produkt ID: 179340672627167670
Gemacht am: 7.2.2021, 19:57
Bewertung: G
Zuletzt angesehene Produkte



